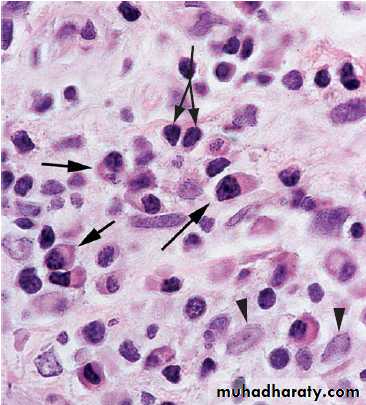
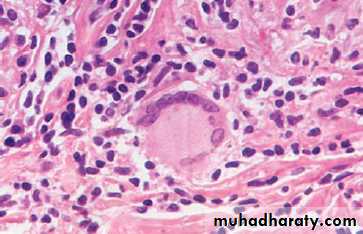

Acute inflammation with densely packed polymorphonuclear neutrophils (PMNs) with multilobed nuclei (arrows), With edema (red arrws).
Acute inflammation with densely packed polymorphonuclear neutrophils (PMNs) with multilobed nuclei (arrows), With edema (red arrws).
Chronic inflammation. Lymphocytes (double-headed arrow), plasma cells (arrows) and a few macrophages (arrowheads) are present.
Chronic inflammation. Lymphocytes (double-headed arrow), plasma cells (arrows) and a few macrophages (arrowheads) are present.
A. Section of lung from a patient with sarcoidosis reveals numerous discrete
granulomas.A. Section of lung from a patient with sarcoidosis reveals numerous discrete
granulomas.
B. A higher-power photomicrograph of a single granuloma in a lymph node from the same patient depicts a multinucleated giant cell amid numerous pale epithelioid cells. A thin rim of fibrosis separates the granuloma from the lymphoid cells of the node.
B. A higher-power photomicrograph of a single granuloma in a lymph node from the same patient depicts a multinucleated giant cell amid numerous pale epithelioid cells. A thin rim of fibrosis separates the granuloma from the lymphoid cells of the node.
A Langhans giant cell shows nuclei arranged on the periphery of an abundant cytoplasm.
A Langhans giant cell shows nuclei arranged on the periphery of an abundant cytoplasm.A foreign body giant cell has numerous nuclei randomly arranged in the cytoplasm.
A microscopic section shows regenerating nodules (red ) surrounded by bands of connective tissue (blue).
Many glomeruli have been destroyed and appear as circular scars (arrows).
Traumatic neuroma. In this photomicrograph, the original nerve (arrows) enters the neuroma. The nerve is surrounded by dense collagenous tissue, which appears dark blue with this trichrome stain. Excessive repair obstructs axonal reconnection.